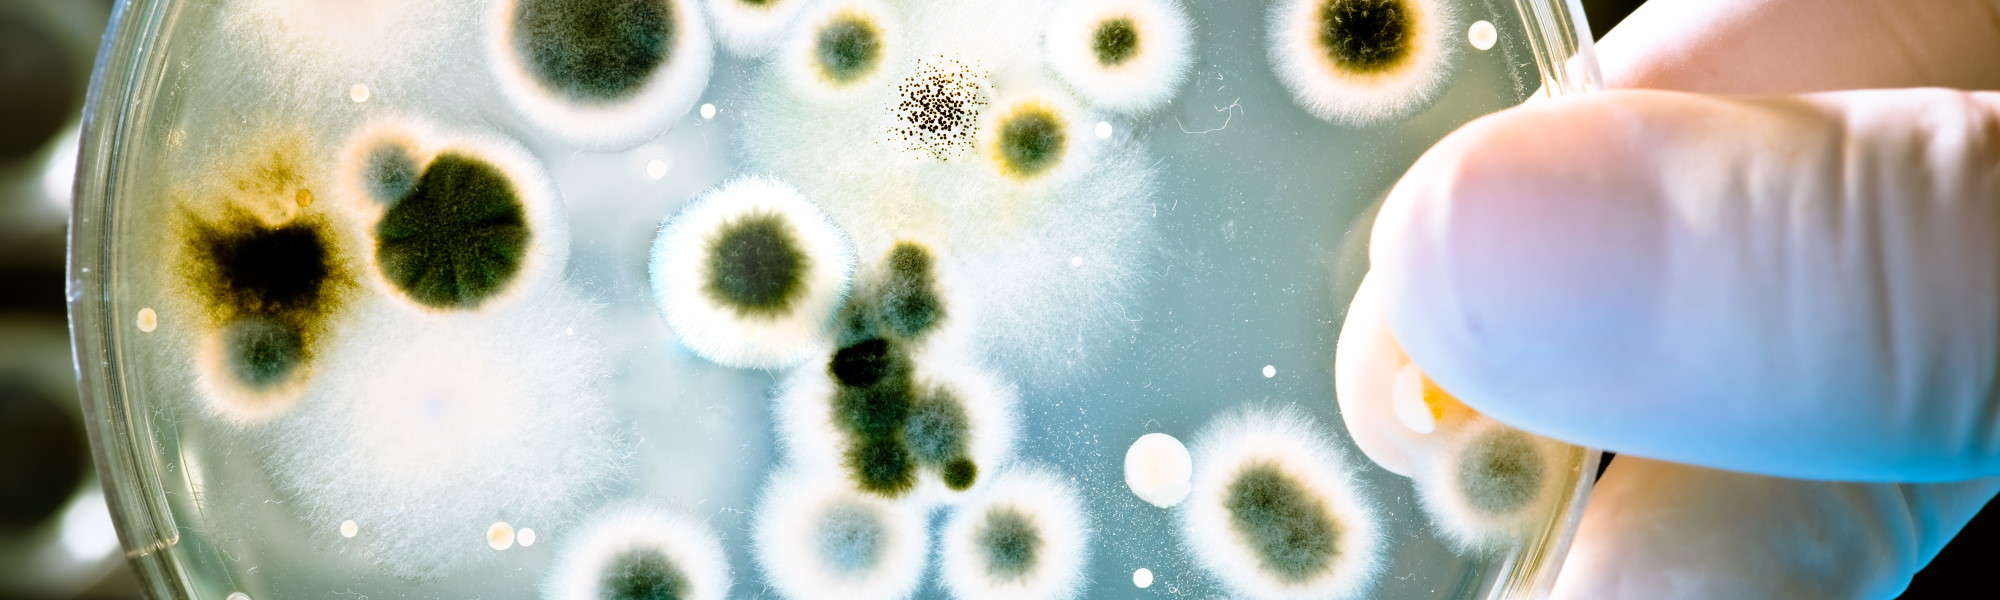
Treescience

Using the latest scientific principles for plant and soil health care, we can also apply a range of cost-saving tree fertilising techniques and management strategies, that are designed to complement the surrounding environment and develop a healthier food soil profile.
Applying industry-leading tools such as Grow-gun, Air Knife, Microscopic Analysis and Wood/Soil DNA Sequencing removes speculation, allowing an advanced understanding of a tree’s structure, soil microbiology and root positioning underground.
We also work closely with Australia’s leading soil biology groups who are committed to assisting urban forest Arborists achieve true sustainable soil fertility, without the need for toxic and costly chemicals.